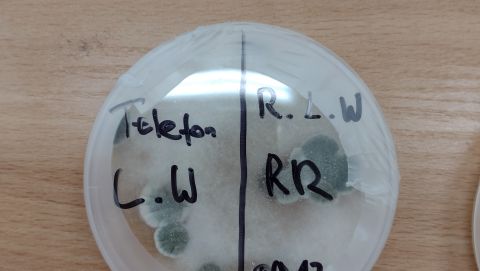
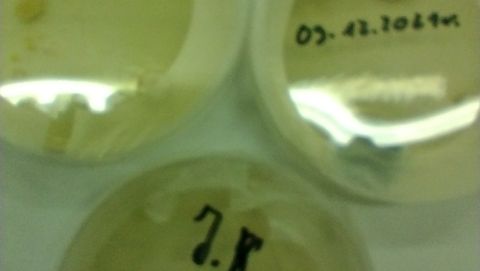

Najbrudniejsza jest maseczka
Na dodatkowych zajęciach przyrodniczych uczniowie klasy 5b i 7a sprawdzali jakie "formy życia" występują na przedmiotach codziennego użytku. W specjalnej pożywce mikrobiologicznej uczniowie odciskali dłonie, pieniądze, telefony, maseczki, wskaźnik, a nawet klamkę drzwi do męskiej toalety. Niestety najwięcej drobnoustrojów wyrosło na hodowlach z odciskami telefonów i maseczek. Wniosek uczniów był jednoznaczny: "Należy częściej zmieniać maseczkę, nie kłaść jej byle gdzie i dezynfekować przedmioty, których się używa."
Tekst: Monika Pietraszko- Warchałowska